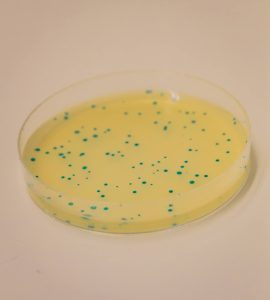
IBB-BERG_IMG-9

Bioprocess Engineering Research Group
Exploring biology-based engineering solutions to optimize/streamline the manufacturing of biological molecules and formulations thereof for Health and Bioeconomy applications
Keywords
Bioprocess Engineering
Biomolecular Engineering
Analytical Biotechnology
Nanobiotechnology
Coordinator
Goals
The Bioprocess Engineering Research Group (BERG)
The Bioprocess Engineering Research Group (BERG) explores biology-based engineering solutions to optimize/streamline the manufacturing of biological molecules and formulations thereof for Health and Bioeconomy applications. We want to improve productivity, scalability, affordability, and access to impactful products. The multidisciplinary team holds scientific expertise in molecular/cell biology, microbiology, bioprocess engineering, nanomedicine, and pharmaceutical technology.
We tackle technological challenges linked to the manufacturing of last generation biomolecules such as antibodies, nucleic acids, proteins and bio-nanostructures and with the development of formulations for encapsulation/delivery of drugs, by designing, developing, and optimizing bioprocessing technologies, analytical tools, assays, and materials. Our research topics span Microbial cell factories, Manufacturing of new modalities, Future biomanufacturing and Formulations for delivery and encapsulation.
Focus Areas
People
The BERG Team
Coordinator
For applications or further information, please get in touch!